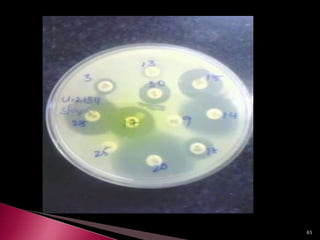
65
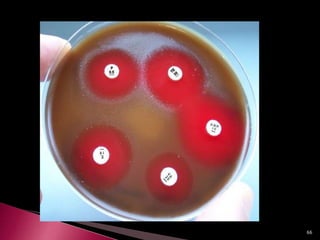
66
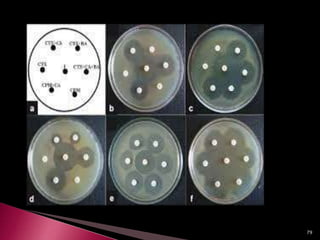
79
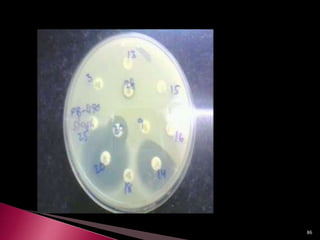
86
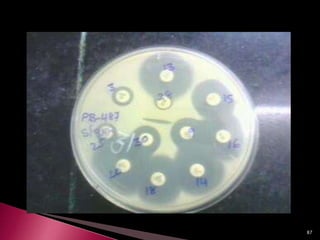
87
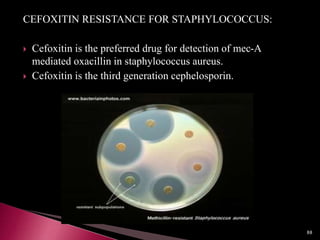
CEFOXITIN RESISTANCE FOR STAPHYLOCOCCUS:
 Cefoxitin is the preferred drug for detection of mec-A
mediated oxacillin in staphylococcus aureus.
 Cefoxitin is the third generation cephelosporin.
88

This document discusses antibiotics and antibiotic resistance. It defines antibiotics as substances produced by organisms that can inhibit or destroy other microorganisms. Ideal antibiotic qualities include killing pathogens without harming the host. Antibiotics can be bactericidal, killing bacteria, or bacteriostatic, inhibiting their growth. Resistance arises through mutation or acquisition of genetic material. It is important to test bacteria and prescribe the appropriate antibiotic to minimize resistance development.